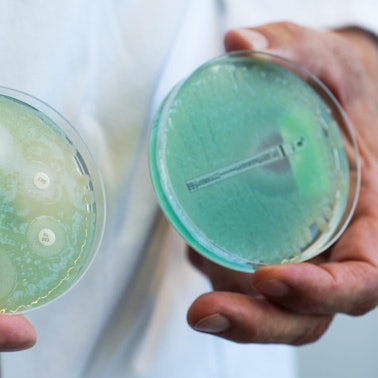
Keime dpa

Fehlende ErfahrungKnapp jede fünfte Klinik entspricht nicht den Mindestanforderungen

Symbolbild
Copyright: dpa
- Jede fünfte Klinik in Deutschland entspricht nicht den gesetzlichen Mindestanforderungen.
- In NRW sind es sogar etwas mehr als 44 Prozent.
- Patienten haben kaum eine Möglichkeit, die Kompetenz ihrer Klinik zu kontrollieren.
Köln – Übung macht den Meister, lautet ein bekanntes Sprichwort. Es trifft auf viele Berufe zu. Vor allem auf das Handwerk. Maurer, Maler oder Metzger sind besser, erfolgreicher, je öfter sie ihre Arbeit gemacht haben. Das gilt aber auch für Ärzte. Operationen sind mitunter reines Handwerk. Ein Chirurg, der einen schwierigen Eingriff schon häufig durchgeführt hat, kennt viele der Komplikationen, die auftreten können. Er ist gewappnet, operiert sicherer als jemand, der sich erst wenige Male an den Eingriff herangetraut hat. Den Patienten kommt das zugute.
Umso mehr überrascht es, dass viele Kliniken die gesetzlichen Mindestanforderungen für schwere, planbare Operationen nicht einhalten. Rund 40 Prozent aller Kliniken, die entsprechende Eingriffe durchführen, erreichen eine oder mehrere der vorgeschriebenen Mindestfallzahlen nicht, wie eine Untersuchung der Bertelsmann-Stiftung und des Kölner Science Media Centers zeigt. In Nordrhein-Westfalen sind es gar 44,5 Prozent der Kliniken. Nicht jede Klinik des Landes nimmt an der Mindestmengenversorgung teil. Gemessen an allen Kliniken erfüllen 23,6 Prozent die Vorgaben nicht.
Der Gemeinsame Bundesausschuss, das höchste Beschlussgremium im Gesundheitswesen, hat seit 2004 bisher nur bei sieben medizinischen Eingriffen Mindestmengen festgelegt: bei Leber- und Nierentransplantationen, komplexen Eingriffen an der Speiseröhre und der Bauchspeicheldrüse, Stammzelltransplantationen, beim Einsatz von künstlichen Kniegelenken sowie bei der Versorgung von Früh- und Neugeborenen mit einem Geburtsgewicht von unter 1250 Gramm. Notfälle fallen grundsätzlich nicht darunter.
Patienten können kaum kontrollieren
Für die Patienten sind die OP-Zahlen nur schwer einsehbar. Zwar müssen die Kliniken sie in den jährlichen Qualitätsberichten veröffentlichen, doch werden sich nur wenige Patienten in der Materie soweit auskennen, um die entsprechenden Passagen in den Berichten zu finden.
Besonders häufig verfehlen die Kliniken die Mindestfallzahl bei komplexen Speiseröhren- und Bauchspeicheldrüsen-Operationen. Diese liegt jeweils bei zehn im Jahr. Von 376 Kliniken, die schwierige Operationen an der Speiseröhre (Ösophagus) vorgenommen haben, erreichte über die Hälfte (52,6 Prozent) die Mindestmenge nicht. Bei komplexen Operationen an der Bauchspeicheldrüse (Pankreas) waren es 205 (33,9 Prozent) von 603 Klinken. Hinzu kommen zahlreiche Krankenhäuser, die die Anforderungen nur sehr knapp erfüllen.
Das könnte Sie auch interessieren:
In Kliniken, in denen die Mindestmengen nicht eingehalten werden, ist das Risiko von Komplikationen und Todesfällen nachweislich höher. Für den Mindestmengenbereich der Bauchspeicheldrüsen-Operationen zeigt dies zum Beispiel eine Studie aus dem vergangenen Jahr: Die Forscher aus Erlangen und Berlin hatten alle Fälle von Bauchspeicheldrüsen-Operationen in Deutschland von 2009 bis 2013 analysiert.
Am Ende war klar: In erfahrenen Teams gab es weniger Komplikationen, vor allem aber beherrschten sie die Krisen besser. Kam es zum Schlaganfall, starben in unerfahrenen Kliniken 50 Prozent mehr Patienten als in erfahrenen. Erkrankte der Patient nach der Operation an einer Blutvergiftung, starben in unerfahrenen Krankenhäusern sogar fast 60 Prozent mehr Patienten.
Hohes Risiko ohne Not
Der Berliner Gesundheitsökonom Thomas Mansky kritisiert, dass Patienten ohne Not höheren Risiken ausgesetzt werden. „Meist ist in der Nähe eine andere Klinik zu finden, die mehr Erfahrung hat und bessere Qualität bietet.“ Mansky hatte bis vor Kurzem auch den Lehrstuhl für Strukturentwicklung und Qualitätsmanagement im Gesundheitswesen an der TU Berlin inne. Statt die schwierigen Eingriffe in der Region an wenigen, hochqualifizierten Kliniken zu konzentrieren, würden die Patienten auf so viele Anbieter verstreut, dass am Ende kaum noch ein Krankenhaus genügend Erfahrung aufbauen könne, sagt Mansky. „Wir verteilen Ärzte und Personal, die wir nicht haben, auf Kliniken, die wir nicht brauchen.“

Symbolbild
Copyright: picture alliance/dpa
Der Verstoß gegen die Mindestmengen ist mitunter aber legal, da die Kliniken sogenannte Ausnahmetatbestände geltend machen können. Ein solcher gilt etwa, wenn im Zuge einer Notfallbehandlung auch ein Eingriff aus dem Mindestmengenkatalog durchgeführt werden muss. Die Klinik darf diese Operation dann abrechnen, obwohl sie zum Ende des Jahres die Mindestmenge wohl nicht einhalten wird. Da die Krankenhausplanung Ländersache ist, dürfen auch die Behörden explizit für eine Sondergenehmigung sorgen. Ebenso gibt es eine Schonzeit von 36 Monaten für Kliniken, die einen neuen Fachbereich aufbauen.
Rund 14 Prozent der Krankenhäuser, die wenigstens eine Mindestmenge nicht einhalten, machen dafür Ausnahmetatbestände geltend. Ein Großteil verzichtet allerdings darauf – wodurch die jeweiligen Operationen eigentlich nicht mit den Kassen abgerechnet werden dürfen.Das Lukas-Krankenhaus in Neuss unterschreitet laut aktuellem Qualitätsbericht beispielsweise die Mindestmenge im Bereich der komplexen Speiseröhren-Operationen. Die Klinik gab an, fünf solcher Eingriffe vorgenommen zu haben. Zehn wären aber Pflicht gewesen.
Auf Anfrage teilt die Klinik mit: „Da zu jenem Zeitpunkt bereits ein Wechsel der Klinikleitung mit einem sehr renommierten und erfahrenen Chefarzt im Sommer 2018 feststand, wurden die Operationen im Lukas-Krankenhaus weiter angeboten. Im Jahr 2019 konnte das Team um Prof. Alexis Ulrich bis Mai bereits neun Ösophaguseingriffe erfolgreich durchführen.“ Bis Ende des Jahres dürfte die Klinik die Mindestmenge also höchstwahrscheinlich erreichen.
Keine Genehmigungen in fast 370 Fällen
Doch bei Weitem nicht alle Krankenhäuser können einen triftigen Grund für ihr schlechtes Abschneiden angeben. Bundesweit gibt es für 369 unterschrittene Mindestmengen keine Genehmigung in Form von Ausnahmetatbeständen. Das entspricht 65,8 Prozent. Der Gelegenheitschirurgie leistet das Vorschub. Um dieser entgegenzuwirken, hat der Gemeinsame Bundesausschuss 2017 eine neue Mindestmengenregelung beschlossen, deren Änderungen ab diesem Jahr greifen. So müssen die Kliniken künftig in der Zeit von 30. Juni bis 15. Juli ihre Mindestmengen-Prognose an die Krankenkassen abgeben. Dabei müssen sie im Detail darlegen, ob sie die betreffende Mindestmenge im Folgejahr voraussichtlich erreichen werden. Die Kassen entscheiden dann auf Grundlage dieser Zahlen, welche Krankenhäuser 2020 die Mindestmengen-Eingriffe erbringen dürfen .
Zudem soll es bald einfacher sein, weitere Behandlungen in den Mindestmengenkatalog mit aufzunehmen. Experten bemängeln seit Langem, dass es für zu wenige Eingriffe Mindestmengen gibt und dass diese auch zu niedrig angesetzt sind. So fallen in Deutschland nur 177.000 Operationen jährlich unter die Mindestmengen-Regelung – bei insgesamt 19 Millionen Eingriffen. „Wir müssen hier ordentliche Zahlen ansetzen“, sagt Thomas Mansky. „Nicht zehn Operationen im Jahr, sondern 100.“ Nur so erhalte man den Effekt der Spezialisierung. „Jeder von uns kann sich selbst fragen, ob er nicht lieber bereit wäre, für ein gutes und erfahrenes OP-Team 50 Kilometer weiter zu fahren, statt sich in der weniger erfahrenen Klinik vor der Haustür unters Messer zu legen.“
Großer Bedarf bei Onkologie und Rückenoperationen
Matthias Mohrmann, Vorstandsmitglied der AOK Rheinland/Hamburg, sagt: „Es gibt viele komplexe Eingriffe, bei denen das Krankenhaus ein Mindestmaß an Erfahrung vorweisen sollte. Wir sehen zum Beispiel vor allem Bedarf in der Onkologie und bei Rücken-Operationen.“ Zwar brauche man weiterhin Kliniken, die eine Grund- und Regelversorgung anböten, diese sollten sich aber bei ihrem Angebot limitieren. „Es macht keinen Sinn, dass jede Klinik alles macht. Das birgt die Gefahr der Minderqualität.“ Mohrmann plädiert für eine intelligente Vernetzung von Kliniken der Grund- und Regelversorgung mit spezialisierten Zentren.
Die Krankenhausgesellschaft NRW sieht den Vorstoß des Gemeinsamen Bundesausschusses in Teilen kritisch. „Die Einführung einer Mindestmenge bedeutet nicht in jedem Fall eine Qualitätsverbesserung“, heißt es auf Anfrage. Der Gesetzgeber habe die Anforderungen an Mindestmengen-Operationen mit dem Krankenhausstrukturgesetz herabgesetzt. „Die Einführung von Mindestmengen ist nicht mehr an den Nachweis einer Abhängigkeit der Behandlungsqualität von der erbrachten Leistungsmenge ‚in besonderem Maße' gebunden. Dies halten wir für falsch.“
Tatsächlich wurden die drei Wörter mit der Gesetzesänderung im SGBV gestrichen. In der wissenschaftlichen Literatur reicht nun lediglich ein Hinweis auf den Zusammenhang zwischen Fallzahl und Ergebnisqualität, damit eine neue Mindestmenge eingeführt werden kann. Dies kann Experten zufolge aber eine Weile dauern – nämlich bis zu sechs Jahre.